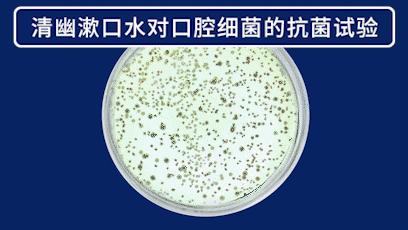
刷完牙嘴里还是有恶臭?那你需要用漱口水了

说一个可能让你很难过的事实——即使每天坚持刷牙,也只能维持表面25%区域的清洁,口腔有75%都是刷牙无法清洁到的死角,例如牙缝、窝沟等盲区根本没有被彻底清洁干净!

据国家卫计委日前公布的第四次全国口腔健康流行病调查数据显示,我国目前35-44岁成年人口腔牙石检出率为96.7%;牙龈出血检出率为87.4%;更让人担忧的是,调查数据显示中国5岁儿童龋患率为71.9%,12岁儿童龋患率为38.5%,与十年前相比,5岁和12岁儿童龋患率分别上升了5.8和7.8个百分点。

想要有效清洁口腔,除了天天认真刷牙外,你还需要——坚持使用漱口水漱口。
特别是吃过东西或者喝过饮料后,呼噜呼噜漱一下,就可以把食物残渣都清理出口腔。这么简单的一个动作,好处可真的不少,不仅可以减少牙菌斑和食物废渣的残留,降低患上口腔疾病的风险,如龋齿、牙周病(牙龈发炎、牙龈出血),还能清新口气,减轻恼人口臭问题。

漱口水这么有效,但是哪款最好用呢?用了不下十几款漱口水,今天来给大家推荐一款自用的最好用的漱口水,没有之一!那就是清幽漱口水。直接买绝对不踩雷!

生物抑菌,安全健康
相较于市面上那些五颜六色、各种化学添加剂的漱口水,这款清幽漱口水主打活性生物抑菌,主要成分是天然生物提取的双重氨基酸和广泛存在于口腔的溶菌酶,入口非常的安心。
像一些漱口水里悄咪咪地加了杀菌剂(普通人谁能知道哪些是杀菌剂呢?),用了当下感觉倒是好,但它机械性地不分好菌坏菌一通乱杀,你也很快就能体验到口腔菌群失调的可怕了(溃疡、牙龈发白等)。
生物抑菌的好处则非常明显,因为它是高活性的,可以根据口腔情况自动进行菌群的平衡和调节,在抑制口腔有害菌的同时,还能促进受损的组织修复,滋养口腔。这就不得不提成分中的高活性生物溶菌酶和高纯度双重氨基酸。
清幽漱口水中的高活性生物溶菌酶在解决口腔问题上,已经有很多科学研究成果,证实它对去除口臭,牙龈肿痛、口腔溃疡、出血甚至蛀牙、牙周病等等口腔问题的积极作用。高纯度双氨基酸成分,可以帮助修复口腔菌群,再塑健康口腔环境。而且,清幽漱口水的PH值接近人体,一点也不刺激,包括孕妇、老人、儿童在内的人群都可以放心使用,长期家庭用都放心的!

味道超好,愉悦体验
漱口水的口味对很多人来说应该都是个重点挑选项!清幽漱口水的香味简直是梦中的味道,太!高!级了!多位专业调香师花大力气调配而成,淡雅的花香,清清柔柔不浓郁,入口后还带有淡淡的茶香,非常有层次感,第一次漱口的时候忍不住都想喝下去。漱口水含在嘴里漱10秒的时候,开始能感受出一丝丝的清凉,但一点也不辣嘴,漱口后清新的感受能持续长达3-5小时,哪怕口中的凉感消失,也依旧能中和抑制口腔味道维持12小时之久。330ml能用很久,出门携带也方便,家里放一瓶,办公室放一瓶,包里一瓶,有了它在,安心许多。
